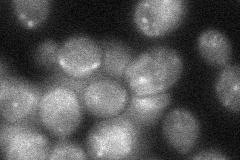
YAL002W
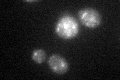
YAL002W

View description
Membrane-associated protein that interacts with Vps21p to facilitate soluble vacuolar protein localization; component of the CORVET complex; required for localization and trafficking of the CPY sorting receptor; contains RING finger motif
Localization:
Intensity:
Fold change:
Significance:
-
C’ GFP library in SD

punctate19.55 -
N' NOP1pr-GFP in SD

punctate68.4383 -
N' TEF2pr-mCherry in SD

punctate49.844 -
N' NATIVEpr-GFP in SD

punctate21.1228 -
N' TEF2pr-VC and Cyto-VN in SD
below threshold31.9132 -
C’ GFP library in SD+DTT
punctate22.861.16No -
C’ GFP library in SD+H2O2

punctate22.541.15No -
C’ GFP library in Starvation Media

punctate20.961.07No -
C’ GFP library on the background of Pup2-DaMP

punctate -
C’ GFP library on the background of CCT mutant

punctate17.11470.874906No
